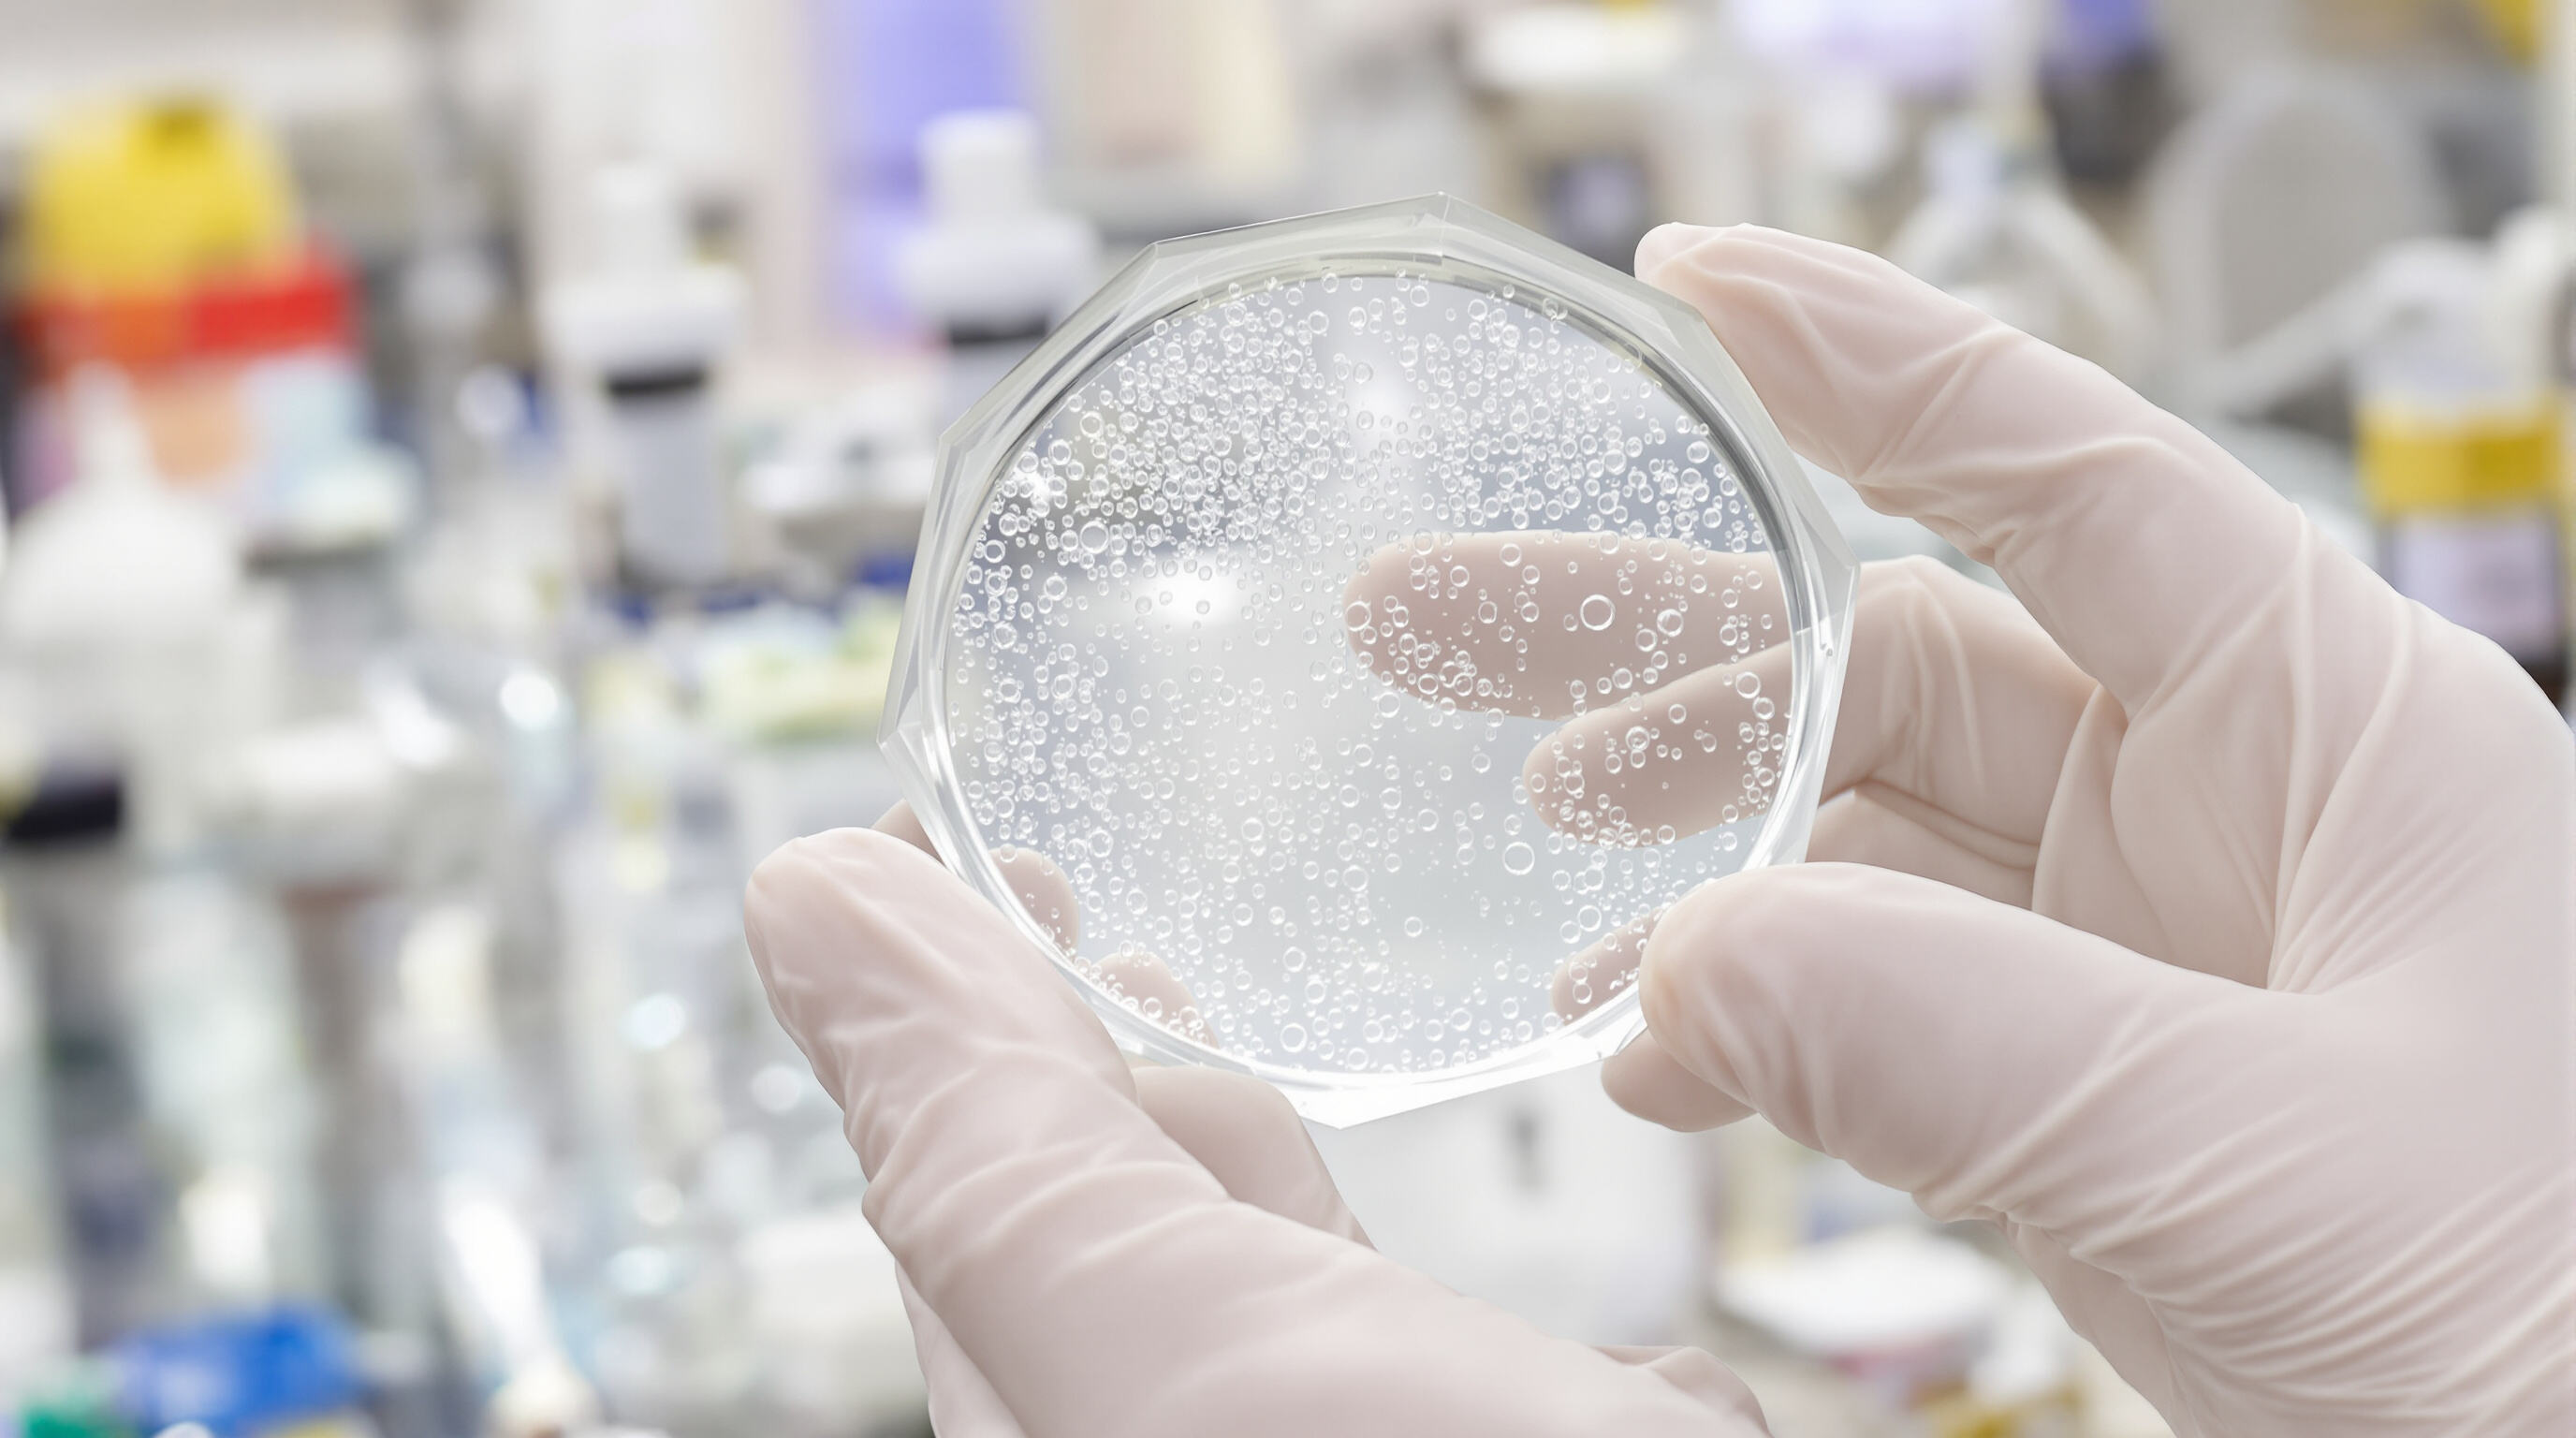

HA filler ဖွံ့ဖြိုးတိုးတက်မှုတွင် ပုံစံတူဖန်တီးပေးမှု၏ အဆင့်တိုးတက်မှု
ပုဂ္ဂိုလ်ရေးအလှအပဆိုင်ရာဖြေရှင်းချက်များအတွက် တောင်းဆိုမှုများ တိုးပြားလာခြင်း
၂၀၂၁ ခုနှစ်မှ ယခုအချိန်အထိ အလှအပဆေးဘက်ဆိုင်ရာနယ်ပယ်တွင် လိုအပ်သည့် HA (Hyaluronic Acid) ဖြည့်စွက်ပစ္စည်းများအတွက် ဝယ်လိုအားမှာ အများဆုံး ၆၄% ခုနှစ်တိုးတက်မှုရှိခဲ့သည်။ လူနာများသည် သဘာဝကျကျ ရလဒ်များကို ရရှိနိုင်ရန် လိုလားကြပြီး အထင်အရှားမြင်တွေ့ရသည့်အရာများကို မလိုလားကြပါ။ သူတို့၏ မျက်နှာအစိတ်အပိုင်းများနှင့် ကိုက်ညီသည့် အရာများကိုသာ လိုလားကြပြီး အများအားဖြင့် အကျိုးရှိသည့် စံနှုန်းများကိုတော့ မလိုလားကြပါ။ ယနေ့ခေတ်တွင် ဆရာဝန်များသည် တစ်ခုတည်းဖြင့် အားလုံးအတွက် အသုံးပြုနိုင်သည့် ကုသမှုများမှ ရွေ့ပြောင်းလာကြပါသည်။ HA ဖြည့်စွက်ပစ္စည်းများကို စံနှုန်းအတိုင်း အသုံးပြုခြင်းထက် လူနာတစ်ဦးချင်းအတွက် ပုံစံချပေးသည့် အသုံးပြုမှုကို အသုံးပြုပါက လူနာများ၏ ကျေနပ်မှုနှုန်းသည် ပိုမိုကောင်းမွန်သည်ကို ဆေးပေးသူများထဲမှ လူတိုင်း၏ သုံးပုံနှစ်ပုံက သတိပြုမိကြပါသည်။ ဤစီးပွားရေးလုပ်ငန်းတွင် အကျိုးရှိသည့် အချက်များကို ဖောက်သည်များက ပိုမိုသိရှိလာသည်နှင့်အမျှ ဤစီးပွားရေးလုပ်ငန်းသည် နှေးကွေးမှုမရှိတော့ပါ။
စံထုတ်ထားသည့် HA ဖြည့်စွက်ပစ္စည်းများမှသည် လူနာတစ်ဦးချင်းအတွက် ပုံစံချပေးသည့် HA ဖြည့်စွက်ပစ္စည်းများသို့ စီးပွားရေးလုပ်ငန်းပြောင်းလဲမှု
အလှအပ မော်ဒယ်များသည် ယေဘုယျ ပုံစံများမှ အသားအရေအထူ၊ လှုပ်ရှားမှုနှင့် ဖျက်စီးမှုနှုန်းများကဲ့သို့သော အချက်များကို ထည့်သွင်းစဉ်းစားထားသည့် အက်ဒီပါတစ် အိုင်ဒရိုဖြည့်စွက် စနစ်များသို့ ပြောင်းလဲလျက်ရှိပါသည်။ နောင်တွင် ထုတ်လုပ်သူများ၏ လုပ်ငန်းခွင့်ပြုချက်များအရ ထုတ်ကုန်တန်းစီတစ်ခုလျှင် အနည်းဆုံး အတွဲနှစ်ခုကို ပေးဆောင်းနေပြီဖြစ်သည်။ ကုသမှုအတွင်း ဖြည့်စွက်ဆေးများကို တွဲဖက်သုံးစွဲရန် ပညာရှင်များအား ခွင့်ပြုပါသည်။
လူနာများ၏ ပရိုဖိုင်ကို ပုံစံတစ်ခုအဖြစ် ပုံစံထုတ်ထားသော HA ဖြည့်စွက်မှု ဒီဇိုင်းတွင် ပေါင်းစပ်ခြင်း
HA ဖြည့်စွက်မှု ဖွံ့ဖြိုးတိုးတက်မှုကို အသိအမှတ်ပြုသော နည်းပညာများကို ပုံစံသစ်များဖြင့် ပြုလုပ်နေပါသည်-
- 3D မျက်နှာပြင်မှာ အတိုင်းအတာများကို အက်ဒီပါတစ် အိုင်ဒရို ဖြည့်စွက်မှု လိုအပ်ချက်များကို လမ်းညွှန်ပါသည်
- Collagen သိပ်သောနှုန်းများကို ဖြည့်စွက်ဆေးများ၏ အကောင်းဆုံး အဆင့်ကို ဆုံးဖြတ်ပါသည်
- လူမျိုးအလိုက် ပုံစံထုတ်ထားသော အချက်အလက်များကို အသုံးပြု၍ အသားအရေအမျိုးအစားများအတွက် အကောင်းမြင်ရလဒ်များကို တိုးတက်စေပါသည်
နာမည်ကျော် မော်ဒယ်များသည် ပုံစံတစ်ခုအဖြစ် HA ဖြည့်စွက်မှု စွမ်းဆောင်ရည်ကို မည်ကဲ့သို့ အသုံးပြုနေပါသနည်း
ထိပ်တန်းထုတ်လုပ်သူများသည် နည်းစနစ် သုံးမျိုးကို အသုံးပြုပါသည်-
- ပြောင်းလဲနိုင်သော ပလက်ဖောင်းများ ထိုးသွင်းစဉ်တွင် အတိုင်းအတာကို ပြောင်းလဲနိုင်စေပါသည်
- စွမ်းဆောင်ရည်ကွန်းကျူးခြင်း တစ်ရှူး၏ pH နှင့် အပူချိန်ကို အက်ဒေါ့ပ်လုပ်ထားသည့် နည်းပညာများ
- AI အင်ဂျင်ဖြင့် အကြံပြုစနစ် ဇီဝအချက်အလက်များကို ကိုက်ညီသည့် ဆေးထုတ်လုပ်မှု
ဤစိတ်ကူးကို အသုံးချခြင်းဖြင့် ပြန်လည်ပြုပြင်မှုကို ၃၂% လျော့နည်းစေပြီး ထုတ်ကုန်အသုံးပြုနိုင်မှုကို တိုးတက်စေပါသည်။ HA ဖြည့်စွက်ဆေးများ၏ ၆၈% သည် တစ်နှစ်အတွင်း အများဆုံး ပမာဏကို ထိန်းသိမ်းထားနိုင်ပါသည်။
မျှင်တုံးတွင် အောက်စီဂျင်အက်ဆစ်၏ မော်လီကျူး အင်ဂျင်နီယာပညာ
မော်ဒန် ဟိုက်ယာလူရွနစ်အက်ဆစ်ဖီလာများ ဖွံ့ဖြိုးတိုးတက်လာမှုမှာ မော်လီကျူး အင်ဂျင်နီယာရင်းနှင့် အလှအပဆိုင်ရာ ပြဿနာများစွာကို ဖြေရှင်းနိုင်သည့် နည်းပညာများကြောင့် အမှန်တကယ် တိုးတက်လာခဲ့ပါသည်။ ဓာတုပစ္စည်းများ အမှန်အကန် ပြုပြင်ပေးခြင်းဖြင့် ထုတ်လုပ်သူများသည် ဟိုက်ဒရိုဂျယ်များ၏ ယိမ်းယားမှုနှင့် တင်းရင်းမှုတို့ကို မည်သို့ ပြုမူမည်ကို ညှိနှိုင်းနိုင်ပါသည်။ စျေးကွက်တွင် ရရှိနိုင်သော ဟိုက်ယာလူရွနစ်အက်ဆစ်ဖီလာ ၁၀ ခုလျှင် ၈ ခုခန့်တွင် ဖဲ့ထုထည့်ခြင်း သို့မဟုတ် ဆာလဖိတ်ပြုလုပ်ခြင်းတို့ကို ထည့်သွင်းထားပြီး ဖီလာများ၏ ဖောင်းခြင်းနှင့် သဘာဝအားဖြင့် ပျက်စီးမှုကို ခုခံနိုင်မှုကို တိုးတက်စေပါသည်။ အထူးသဖြင့် BDDE ဟုခေါ်သော နည်းပညာနှင့် ဖြစ်သော ခရော့စ်လင့်ခ်နည်းပညာတွင် ဆရာဝန်များသည် ရလဒ်များ မည်မျှကြာရှည်စေရန်ကို ပိုမိုကောင်းမွန်စွာထိန်းချုပ်နိုင်ပါသည်။ အချို့ထုတ်ကုန်များသည် ၉ လမှ ၁၈ လအထိ ထိရောက်မှုရှိပြီး အများအားဖြင့် ၁၂.၅% မှ ၁၇.၅% အထိ ခရော့စ်လင့်ခ်ပြုလုပ်ထားသည့်အခါတွင် ပိုမိုကောင်းမွန်ပါသည်။ မော်လီကျူးဝိသေစနှင့် ရွေးချယ်မှုသည် ကြီးမားသော ကွာခြားမှုကို ဖြစ်ပေါ်စေပါသည်။ မော်လီကျူးဝိသေစ ပိုများသော ဖီလာများသည် ပုံမှန်အားဖြင့် ၂၃% ပိုမိုထုထည့်ပေးနိုင်သည်ဟု လေ့လာမှုများအရ သိရပြီး ဖွဲ့စည်းပုံကို ထည့်သွင်းရန်အတွက် ကောင်းမွန်ပါသည်။ မော်လီကျူးဝိသေစနည်းသော ရွေးချယ်စရာများသည် မျက်လုံးအောက်ရှိ အရေပြားများကဲ့သို့ အရေပြားများကို ပြုပြင်ရန်အတွက် ပိုမိုကောင်းမွန်ပါသည်။ အများစုကော်စမက်စပြုသူများသည် ဖီလာများကို တစ်ဦးချင်းစီ၏ အရေပြား၏ အထူးသွေးသားနှင့် ဇီဝဖြစ်စဉ်နှုန်းကို ကိုက်ညီစေရန် ရွေးချယ်ပေးသည့်အခါတွင် ပိုမိုကောင်းမွန်သော ရလဒ်များကို သတိပြုမိကြပါသည်။ ထို့ကြောင့် တစ်ဦးချင်းစီအတွက် အထူးသဖြင့် အသုံးပြုနိုင်သော ဖီလာများကို အသုံးပြုရန် ရွေ့ပြောင်းလာနေပါပြီ။
အရည်ပိုင်းဆိုင်ရာ ဂုဏ်သတ္တိများကို အကောင်းဆုံးဖြစ်အောင် ပြုလုပ်ခြင်းသည် ထိုးနှံနိုင်မှုနှင့် ပေါင်းစပ်နိုင်မှုကို မြှင့်တင်ပေးသည်။

ဟေးလူရှိုနစ် အက်စစ်ဖြည့်စွက်ရာတွင် ဓာတ်ခန်းတွင် တီထွင်မှုများကို လက်တွေ့တွင် အသုံးချနိုင်ရန်အတွက် အရည်ပိုင်းဆိုင်ရာ ဂုဏ်သတ္တိများကို တိကျစွာ ပြုလုပ်ခြင်းသည် အရေးကြီးပါသည်။ ဤပုံစံများကို ဖန်တီးရာတွင် အရေးကြီးသော အချက်သုံးချက်ရှိပါသည်။ ပထမအချက်မှာ ယိမ်းယားမှု မိုဒူလပ်စ် သို့မဟုတ် G' ဖြစ်ပြီး ထိုးနှံပြီးနောက်တွင် ထုတ်ကုန်သည် တစ်ရှူးများကို မည်မျှထောက်ပံ့ပေးနိုင်သည်ကို ဆုံးဖြတ်ပေးသည်။ နောက်တစ်ချက်မှာ ဖြည့်စွက်ရာတွင် အပ်များအတွင်း ဖြည့်စွက်မှု မည်မျှလွယ်ကူစေသည်ကို သက်ရောက်စေသော အရည်ပျော့ချိန်ဖြစ်ပါသည်။ နောက်ဆုံးအချက်မှာ ထိုးနှံသည့်အခါ လူနာ၏ သက်တောင့်သက်သာကို သက်ရောက်စေသော ဖိအားဖြစ်စေသည့် အင်အားဖြစ်ပါသည်။ ဤနယ်ပယ်ရှိ ကုမ္ပဏီများစွာသည် နောက်ပိုင်းတွင် အရည်ပိုင်းဆိုင်ရာ မှန်ဘီလူးနှုန်းကို အသုံးပြုလာကြပါသည်။ Burckbuchler နှင့် သူ၏ လုပ်ဖော်ကိုင်ဖက်များ၏ 2010 ခုနှစ်က သုတေသနအရ ဤနည်းပညာသည် စမ်းသပ်မှုများ မစတင်မီ ကုန်ပစ္စည်းများ၏ စွမ်းဆောင်ရည်ကို ၉၄ ရာခိုင်နှုန်းခန့် ကြိုတင်ခန့်မှန်းနိုင်ပါသည်။
အရည်ပိုင်းဆိုင်ရာ အဓိကညွှန်းကိန်းများ- G', အရည်ပျော့ချိန်၊ ဖိအားဖြစ်စေသည့် အင်အား
ယိမ်းယိုင်မှု မော်ဒူးလပ် (G') သည် ဖြည့်စွက်ပစ္စည်း၏ ပုံစံကို ခံနိုင်ရည်ရှိမှုကို ဆုံးဖြတ်ပေးသည်။ သာမန်လှုပ်ရှားမှုအတွက် အများအားဖြင့် 150–400 Pa ကို လိုအပ်သည်။ 50 Pa·s ထက်နိမ့်ပါးသော ဒြပ်ထုပ်လိုက် ပျော့ပြောင်းမှုသည် အပ်ကြိုးကို ပိုမိုချောမွေ့စေပြီး 20N ထက်နိမ့်ပါးသော ဖိအားသည် ကုသပေးသူများ၏ ပင်ပန်းမှုကို ကာကွယ်ပေးသည်။ တိုးတက်လာသော ဗစ်ကိုအီလက်စတစ် ခွဲခြမ်းစိတ်ဖြာသူများသည် ယခုအချိန်တွင် 22-gauge အပ်ကြိုးထက်ငယ်သော အပ်ကြိုးများကို အသုံးပြု၍ ဤစံသတ်မှတ်ချက်များကို တစ်ပြိုင်နက် မြှပ်နှံပေးနိုင်ပါသည်။
ထိုးဖောက်ခြင်းခံရမှုကို လျော့နည်းစေရန် ပုံစံဖော်ခြင်းနည်းလမ်းများ
ဆာဖက်တန့် ပေါင်းစပ်ခြင်းနှင့် ဆဲလ်ဖြတ်ချိတ်ဆက်မှု သို့မဟုတ် အတူတကွ ချိတ်ဆက်မှု ပြင်းထန်မှု အညွှန်းကိန်းကို အသုံးပြုခြင်းသည် HA ဖြည့်စွက်ပစ္စည်းများ၏ အသစ်ပေါ်ထွက်များ၏ 15N အောက်ရှိ ထုတ်လုပ်မှုဖိအားကို 72% အထိ ရရှိစေပြီး အသုံးပြုနိုင်သည့် ကာလကို ထိန်းသိမ်းထားနိုင်သည်။ သီဇိုထရောပစ် အေဂျင့်များသည် အပ်ကြိုးကို ထိုးဖောက်ခြင်းအားဖြင့် ပျော့ပြောင်းမှုကို လျော့နည်းစေပြီး ထိုးဖောက်ပြီးနောက်တွင် ပုံစံကို အမြန်ပြန်လည်ရရှိစေသည်။ 2024 ခုနှစ်တွင် ပြုလုပ်ခဲ့သော ပစ္စည်းများသိပ္ပံ လေ့လာမှုအရ လစ်ပိုဆိုမ်များဖြင့် ပြုပြင်ထားသော HA ဟိုက်ဒရိုဂဲလ်များသည် အများအားဖြင့် ပြုပြင်ထားသော ပုံစံများနှင့် နှိုင်းယှဉ်ပါက ထိုးဖောက်သောဖိအားကို 38% လျော့နည်းစေသည်ဟု တွေ့ရှိခဲ့ပါသည်။
လေ့လာမှုအမှတ်စဉ်- အသားပေါ်သို့ ပိုကောင်းမွန်စေရန် ပျော့ပြောင်းမှုကို ညှိနှိုင်းခြင်း
နှစ် ၂၀၁၅ ခုနှစ်တွင် အသားပြင်အလွှာအတွင်းတွင် အသုံးပြုသည့် အတုံးအချင်းအမျိုးအစား သုံးမျိုးကို နှိုင်းယှဉ်လေ့လာခဲ့ပါသည်။ အလယ်အလတ်အတုံးအချင်း (35 Pa·s) သည် အတုံးအချင်းပိုများသည့် အစားထိုးနည်းများနှင့် နှိုင်းယှဉ်ပါက ဇီဝဆဲလ်တည်ဆောက်မှုအပေါ် ၂၃% ပိုမိုကောင်းမွန်ပြီး ၆လအကြာတွင် ၉၈% တည်ဆောက်မှုကို ထိန်းသိမ်းထားနိုင်ခဲ့ပါသည်။ ဤကောင်းမွန်သော ချဉ်းကပ်မှုမှာ HA ဖြည့်စွက်ဆေးဝါးများ၏ ၈၉% ကို ဖွံ့ဖြိုးတိုးတက်မှုလမ်းကြောင်းကို အခြေခံပေးထားပါသည်။
HA ဖြည့်စွက်ဆေးဝါးများတွင် တည်ငြိမ်မှု၊ ကြာရှည်ခံမှုနှင့် ဇီဝဆိုင်ရာ သဟဇာတဖြစ်မှုကို သေချာစေရန်
HA ဖော်မြူလာများ၏ ဇီဝအတွင်း ပျက်စီးမှုပုံစံများနှင့် ဟိုက်ဒရိုဂဲလ်၏ တည်ငြိမ်မှု
HA ဖြည့်စွက်ဆေးဝါးများသည် ပျက်စီးမှုနှုန်းနှင့် ကြာရှည်ခံမှုကို မျှတစွာထိန်းညှိရန် တိကျသော အင်ဂျင်နီယာဒီဇိုင်းကို လိုအပ်ပါသည်။ ဟိုက်ဒရိုဂဲလ်များသည် ကွန်ရက်ဖြင့် တည်ဆောက်ထားသည့် ၆-၁၂ လအထိ တည်ငြိမ်မှုကို ထိန်းသိမ်းထားနိုင်ပါသည်။ ဤတည်ငြိမ်မှုမှာ HA ချိတ်ဆက်များမှ ဖြစ်ပေါ်သော ၃D ကွန်ရက်များကြောင့် ဖြစ်ပြီး ဇီဝဓာတ်ကို ခုခံကာ တဖြည်းဖြည်း အာဟာရဓာတ်များကို စိမ့်ဝင်စေပါသည်။ ဤသည်မှာ အသားပြင်အလွှာကို သဟဇာတဖြစ်စေရန် အရေးကြီးပါသည်။
ကြာရှည်ခံမှုကို တိုးတက်စေရန် ကွန်ရက်ဖြင့် ချိတ်ဆက်မှု သိသိသာသာကို ထိန်းချုပ်ခြင်း
ကွဲပြားသော ဆေးပေးမှုများတွင် ကျန်းမာရေးဆိုင်ရာ အချက်အလက်များအရ ကရောက်လင်ခ်ကိန်း ၄-၆% ပါဝင်မှုသည် ၉-၁၂ လအထိ ကြာရှည်ခံမှုကို ဖော်ပြပါသည်။ ကရောက်လင်ခ်လွန်ကဲသော ထုတ်ကုန်များတွင် (၈% ထက်မနည်း) အတွင်းပိုင်း ဖိအားကို ၄၀% တိုးမြှင့်ကာ ဂရန်ယူလိုမာဖြစ်ပေါ်မှုကို ၃၁% ပိုမိုများပြားစေပါသည်။ အဆိုပါအချက်သည် မော်လီကျူးဒီဇိုင်းများအတွက် လိုအပ်သော အမျှတဆုံးဖြတ်မှုကို ဖော်ပြပါသည်။
တိုးတက်သော ပြုပြင်ဆောင်ရွက်မှုများမှတစ်ဆင့် ဇီဝလိုက်ဖက်မှုကို အများဆုံးဖြစ်စေခြင်း
အဆင့်မြင့် အများဆုံးဖြစ်သော ထုတ်လုပ်သူများသည် အများဆုံးဖြစ်သော နည်းလမ်းများနှင့် နှိုင်းယှဉ်ပါက EU/mL ၀.၀၅ အောက်ရှိ အဆိပ်အတောက်များကို ၉၈% လျော့နည်းစေသော အများဆုံးဖြစ်သော အဆင့်များကို အသုံးပြု၍ ရရှိပါသည်။ BDDE ကျန်ပစ္စည်းများကို ppm ၂ အောက်သို့ ဖယ်ရှားခြင်းနှင့် တွဲဖက်ပါက ကလီနစ်စင်တာ ၁၂ ခုမှ စျေးကွက်မှထုတ်လုပ်သော အချက်အလက်များအရ အလွန်အကျူးများပြားမှုကို ၆၃% လျော့နည်းစေပါသည်။
HA အခြေခံထားသော ထိုးဆေးပါ ဇီဝပစ္စည်းများတွင် ရောင်ရမ်းမှုကို အနည်းဆုံးဖြစ်စေခြင်း
မက်ခရိုဖေ့ခ် နှိုးဆော်မှုသည် ပုံမှန်ထုတ်လုပ်မှုထက် ၅၇% နှေးကွေ့သော HA အမှုန့်များ (၁၈၀–၂၅၀ မိုက်ခရိုမီတာ အချင်း) သည် စမ်းသပ်မှုအသစ်များတွင် ၆လအကြာတွင် လူနာ၏ ၉၁% ကျေနပ်မှုကို ပေးသည်။ methoxy PEG-23 ကဲ့သို့သော အောက်ဆီဂျင်ဓာတ်ခုခံနိုင်သော ပေါင်းစပ်ပစ္စည်းများနှင့် တွဲဆက်သောအခါတွင် ဤတီထွင်မှုများသည် လူနာ၏ ၉၁% ကျေနပ်မှုကို ပေးသည်။
HA ဖြည့်စွက်ဆေးပြားနည်းပညာတွင် တီထွင်ဖန်တီးမှုများနှင့် အနာဂတ်တွင်ဖြစ်နိုင်သော တိုးတက်မှုများ
$7.24 ဘီလီယံ HA ဖြည့်စွက်ဆေးပြားဈေးကွက် (2025 ခုနှစ်အတွက် စီးပွားရေးစုံစမ်းမှုကော်မတီ) သည် မျက်နှာကို ဖြည့်စွက်ပေးခြင်းထက် ပိုမိုတိုးတက်လာပြီး ထုတ်လုပ်သူများသည် အလှအပနှင့် ဆေးပညာဆိုင်ရာ လိုအပ်ချက်များကို ဖြည့်ဆည်းပေးသော ပုံစံအသစ်များကို တီထွင်နေပါသည်။ လူနာများ၏ လုပ်ဆောင်မှုဆိုင်ရာ တိုးတက်မှုနှင့် ပိုမိုကြာရှည်သော ရလဒ်များကို တောင်းဆိုမှုကြောင့် ဤနယ်ပယ်သည် ၂၀၂၉ ခုနှစ်အထိ ၁၁.၃% CAGR ဖြင့် တိုးတက်လျက်ရှိသည်။
မျက်နှာကို ဖြည့်စွက်ခြင်းအပြင် - HA ဖြည့်စွက်ဆေးပြားများအတွက် အလှကုန်နှင့် ဆေးပညာဆိုင်ရာ အသုံးပြုမှုများ
ကုမ္ပဏီများသည် မျက်နှာအလှအပအတွက်သာမက လည်ပင်းနေရာကို ပြန်လည်တောက်ပအောင်ပြုလုပ်ခြင်း၊ လက်များကို ပုံစံပြန်လည်ထုတ်လုပ်ခြင်းနှင့် ဒဏ်ရာများကိုပြင်ဆင်ခြင်းတို့အတွက်လည်း HA ဖြည့်စွက်ပစ္စည်းများကို အသုံးပြုလာကြသည်။ ၂၀၂၅ ခုနှစ်က လုပ်ထုံးလုပ်နည်းများအရ ဖြည့်စွက်ကုသမှုများ၏ ၁၈ ရာခိုင်နှုန်းမှာ ဤကဲ့သို့သော လုပ်ထုံးလုပ်နည်းများကို ကိုယ်စားပြုသည်ဟု အစီရင်ခံစာများမှ ဖော်ပြသည်။ ယနေ့ခေတ်ဆေးခန်းများတွင် အောက်ပါအချက်များကို စောင့်ကြည့်လျှင် ဟိုက်ယာလူရွနစ်အက်စစ်သည် မီးခိုးဒဏ်ရာများနှင့် ဓာတုကုထုံးများကြောင့်ဖြစ်သော ပြဿနာများအတွက် ထိရောက်စွာ အလုပ်ဖြစ်နေသည်ဟု သက်သေအထောက်အထားများ ပိုမိုတွေ့ရပါသည်။ အကြီးတန်းနို့ကင်ဆာကုသမှု ခံယူပြီးသော အမျိုးသမီးများသည် ဤကုသမှုများကို ခံယူပြီးနောက် သူတို့၏အသားအရေသည် ပိုမိုကွ့ရှိလာသည်ဟု မကြာသေးမီက ထုတ်ဝေသော လေ့လာမှုတစ်ခုတွင် ဖော်ပြထားသည်။ အသားအရေ၏ ကွ့ယိုင်မှုသည် ၈၂ ရာခိုင်နှုန်းအထိ တိုးတက်မှုရှိသည်ဟု အစီရင်ခံစာတွင် ဖော်ပြသည်။
ထိုးဆေးနှင့် အမှုန့်ဖြည့်ထားသော HA ဇီဝပစ္စည်းအသစ်များ၏ အသုံးပြုမှု
အဓိက တန်းဆင်းနေသော နည်းပညာသုံးမျိုးသည် HA အသုံးပြုမှုကို ပြန်လည်ပုံဖော်နေသည်-
- ဇီဝဖျက်စီးနိုင်သော HA တာဝါတို့ အဆစ်အမျှင်ကိုပြန်လည်ထုတ်လုပ်ရန် (တစ်ရှူးဖွံ့ဖြိုးမှုနှင့် ကိုက်ညီသော ၉၀ ရာခိုင်နှုန်းဖျက်စီးမှုနှုန်း)
- ချိတ်ဆက်ထားသော HA အမှုန့်လေးများ အဆစ်ရောဂါ စီမံခန့်ခွဲမှုတွင် ဆေးဝါးများကို တစ်ပတ်လုံး ထုတ်လွှတ်ပေးနိုင်သော
- 3D ပုံနှိပ်ထားသော HA အစားထိုးအင်ပလန့်များ လူနာ ကျေနပ်မှုနှုန်း 94% ဖြင့် နှာခေါင်းပြန်လည်တည်ဆောက်ခြင်းအတွက်
ဤတိုးတက်မှုများသည် မော်လီကျူးဝိတ် အကောင်းဆုံးဖြစ်အောင် ပြုလုပ်ထားပြီး 1.5–2.0 MDa ဖော်မြူလာများသည် အဆစ်များတွင် စက်ခွဲစိတ်ဆေးရာတွင် စွမ်းအားနှင့် ဇီဝဆိုင်ရာ ပြိုကွဲမှုကြား အကောင်းဆုံး မျှတမှုကို ပြသသည်။
ဆေးပေါင်းစပ်ကုထုံး- HA ဖြည့်စွက်ဆေးများနှင့် ပိုမိုကောင်းမွန်သော ရလဒ်များအတွက် ဇီဝနှိုးဆေးများကို တွဲဖက်အသုံးပြုခြင်း
2024 ခုနှစ်တွင် ဆေးရုံတွင်စမ်းသပ်ခဲ့ရာ HA ဖြည့်စွက်ဆေးများကို ကယ်လ်စီယမ် ဟိုက်ဒရောက်ဆီလ် အပ်တိုက် ဇီဝနှိုးဆေးများနှင့် တွဲဖက်ပါက HA တစ်ခုတည်းထက် ကောလာဂျင်သိုက်ထားမှုကို 43% အထိ တိုးမြှင့်ပေးနိုင်သည်ကို တွေ့ရှိခဲ့သည်။ 2025 ခုနှစ် ကုသမှု ပုံစံများအစီရင်ခံစာအရ ဤနည်းလမ်းနှစ်မျိုးကို တွဲဖက်အသုံးပြုခြင်းဖြင့် ပြန်လည်ကုသမှုများကို 8–12 လအထိ လျော့နည်းစေပြီး အသားအရေ၏ လျော့ယုတ်မှုကို တိုးတက်ကောင်းမွန်စေသည်။ အောက်ပါဇယားသည် အဓိက ဆေးပေါင်းစပ်ကုထုံး၏ အကျိုးကျေးဇူးများကို ပြသသည်-
| ပါရာမီတာ | HA တစ်ခုတည်း | HA + ဇီဝနှိုးဆေး | ပိုကောင်းလာမှု |
|---|---|---|---|
| ကောလာဂျင်သိုက်ထားမှု | +22% | +43% | 95% |
| ကုသမှု ကြာမြင့်မှု | ၉ လ | ၁၆ လ | 78% |
| လူနာ ကျေနပ်မှု | 84% | 93% | 11% |
FAQ အပိုင်း
HA ဖြည့်စွက်ဆေးများ ဆိုသည်မှာ အဘယ်နည်း
HA ဖြည့်စွက်ဆေးများသည် မျက်နှာအသားအရေ၏ ပမာဏကို ဖြည့်တင်းပေးခြင်း၊ အောက်ပါအတိုင်း ညှပ်ခြင်းနှင့် ပုံသဏ္ဍာန်ကို ဖော်ပြခြင်းတို့အတွက် အသုံးပြုသော ဟိုက်ယာလူရွနစ်အက်ဆစ်အခြေခံဖြည့်စွက်ဆေးများဖြစ်ပါသည်။
စိတ်ကြိုက်ပြင်ဆင်ထားသော HA ဖြည့်စွက်ဆေးများသည် ပုံမှန်ဖြည့်စွက်ဆေးများနှင့် မတူညီသောအချက်မှာ အဘယ်နည်း
စိတ်ကြိုက်ပြင်ဆင်ထားသော HA ဖြည့်စွက်ဆေးများသည် ပိုမိုသဘာဝနှင့် ထိရောက်သော ရလဒ်များကို ရရှိစေရန် တိုးတက်သော ဒေတာနှင့် ဖော်မြူလာနည်းပညာများကို အသုံးပြု၍ လူနာတစ်ဦးချင်းစီ၏ ပရိုဖိုင်များအလိုက် ပြင်ဆင်ထားသောဖြည့်စွက်ဆေးများဖြစ်ပါသည်။
HA ဖြည့်စွက်ဆေးများသည် ဘေးကင်းပါသလား
HA ဖြည့်စွက်ဆေးများကို ယေဘုယျအားဖြင့် ဘေးကင်းပြီး အန္တရာယ်နည်းပါးသည်ဟု မှတ်ယူထားပြီး တိုးတက်သော သန့်စင်သည့်လုပ်ငန်းစဉ်များကြောင့် အဆိပ်အတောက်ပါဝင်မှုကို လျော့နည်းစေပါသည်။
ဆေးဘက်ဆိုင်ရာ ရည်ရွယ်ချက်များအတွက် HA ဖြည့်စွက်ဆေးများကို အသုံးပြုနိုင်ပါသလား
ဟုတ်ကဲ့၊ HA ဖြည့်စွက်ဆေးများကို မီးခိုးဖြစ်ခြင်းနှင့် ဓာတ်ရောင်ခြင်းကုသမှုများကဲ့သို့သော ဆေးပညာဆိုင်ရာကုသမှုများတွင် အသားအရေပြန်လည်ထူထောင်ရေးအတွက် အသုံးပြုနိုင်သည်။
HA ဖြည့်စွက်ဆေးနည်းပညာ၏ အနာဂတ်တွင် မည်သည့်အရာကို မျှော်လင့်နိုင်မည်နည်း။
HA ဖြည့်စွက်ဆေးနည်းပညာ၏ အနာဂတ်တွင် အလှအပနှင့် ဆေးပညာဆိုင်ရာ အသုံးပြုမှုများတွင် ပေါ်ထွန်းလာမည့် အသုံးပြုမှုများအပြင် ဇီဝဆိုင်ရာ ကိုက်ညီမှုနှင့် အသုံးပြုနိုင်သည့် ကာလကြာရှည်မှုတို့တွင် တီထွင်ဆန်းသစ်မှုများ ပါဝင်လိမ့်မည်။
အကြောင်းအရာများ
-
HA filler ဖွံ့ဖြိုးတိုးတက်မှုတွင် ပုံစံတူဖန်တီးပေးမှု၏ အဆင့်တိုးတက်မှု
- ပုဂ္ဂိုလ်ရေးအလှအပဆိုင်ရာဖြေရှင်းချက်များအတွက် တောင်းဆိုမှုများ တိုးပြားလာခြင်း
- စံထုတ်ထားသည့် HA ဖြည့်စွက်ပစ္စည်းများမှသည် လူနာတစ်ဦးချင်းအတွက် ပုံစံချပေးသည့် HA ဖြည့်စွက်ပစ္စည်းများသို့ စီးပွားရေးလုပ်ငန်းပြောင်းလဲမှု
- လူနာများ၏ ပရိုဖိုင်ကို ပုံစံတစ်ခုအဖြစ် ပုံစံထုတ်ထားသော HA ဖြည့်စွက်မှု ဒီဇိုင်းတွင် ပေါင်းစပ်ခြင်း
- နာမည်ကျော် မော်ဒယ်များသည် ပုံစံတစ်ခုအဖြစ် HA ဖြည့်စွက်မှု စွမ်းဆောင်ရည်ကို မည်ကဲ့သို့ အသုံးပြုနေပါသနည်း
- မျှင်တုံးတွင် အောက်စီဂျင်အက်ဆစ်၏ မော်လီကျူး အင်ဂျင်နီယာပညာ
- အရည်ပိုင်းဆိုင်ရာ ဂုဏ်သတ္တိများကို အကောင်းဆုံးဖြစ်အောင် ပြုလုပ်ခြင်းသည် ထိုးနှံနိုင်မှုနှင့် ပေါင်းစပ်နိုင်မှုကို မြှင့်တင်ပေးသည်။
-
HA ဖြည့်စွက်ဆေးဝါးများတွင် တည်ငြိမ်မှု၊ ကြာရှည်ခံမှုနှင့် ဇီဝဆိုင်ရာ သဟဇာတဖြစ်မှုကို သေချာစေရန်
- HA ဖော်မြူလာများ၏ ဇီဝအတွင်း ပျက်စီးမှုပုံစံများနှင့် ဟိုက်ဒရိုဂဲလ်၏ တည်ငြိမ်မှု
- ကြာရှည်ခံမှုကို တိုးတက်စေရန် ကွန်ရက်ဖြင့် ချိတ်ဆက်မှု သိသိသာသာကို ထိန်းချုပ်ခြင်း
- တိုးတက်သော ပြုပြင်ဆောင်ရွက်မှုများမှတစ်ဆင့် ဇီဝလိုက်ဖက်မှုကို အများဆုံးဖြစ်စေခြင်း
- HA အခြေခံထားသော ထိုးဆေးပါ ဇီဝပစ္စည်းများတွင် ရောင်ရမ်းမှုကို အနည်းဆုံးဖြစ်စေခြင်း
- HA ဖြည့်စွက်ဆေးပြားနည်းပညာတွင် တီထွင်ဖန်တီးမှုများနှင့် အနာဂတ်တွင်ဖြစ်နိုင်သော တိုးတက်မှုများ
-
FAQ အပိုင်း
- HA ဖြည့်စွက်ဆေးများ ဆိုသည်မှာ အဘယ်နည်း
- စိတ်ကြိုက်ပြင်ဆင်ထားသော HA ဖြည့်စွက်ဆေးများသည် ပုံမှန်ဖြည့်စွက်ဆေးများနှင့် မတူညီသောအချက်မှာ အဘယ်နည်း
- HA ဖြည့်စွက်ဆေးများသည် ဘေးကင်းပါသလား
- ဆေးဘက်ဆိုင်ရာ ရည်ရွယ်ချက်များအတွက် HA ဖြည့်စွက်ဆေးများကို အသုံးပြုနိုင်ပါသလား
- HA ဖြည့်စွက်ဆေးနည်းပညာ၏ အနာဂတ်တွင် မည်သည့်အရာကို မျှော်လင့်နိုင်မည်နည်း။